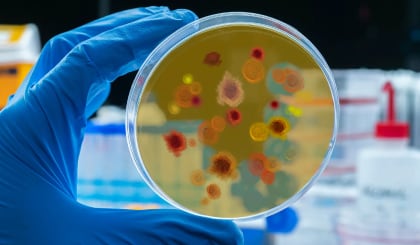

Pioneering life saving research championing education for all

Global perspectives real world impact

Global Child Health
Newly discovered viruses in parasitic nematodes could change our understanding of how they cause disease
Wednesday 25 September 2024
Neonatal Nutrition Network
Professor Najla Al-Sonboli will deliver our 125th anniversary Leverhulme Lecture
Wednesday 25 September 2024
-
Neonatal Nutrition Network
Targeted gene editing could limit spread of insect-borne disease
Wednesday 25 September 2024
-
HIV
Snakebites can destroy skin, muscle, and even bone – exciting progress on drugs to treat them
Friday 27 September 2024
-
Vector Biology
LSTM researcher receives Academy of Medical Sciences Springboard Award
Friday 4 October 2024
Shaping global health since 1898
Founded in 1898 as the UK’s first school of tropical medicine, LSTM has been at the forefront of tackling infectious and neglected diseases for over 125 years. Our pioneering research, world-class education, and global partnerships drive innovative solutions to improve health outcomes and reduce inequalities for the world’s most vulnerable populations.
Discover more about LSTM
Our impact
Through its research, LSTM strives to enhance health for vulnerable populations globally, making significant contributions to the knowledge and practices in global health.
Leading global health innovation

Discover our work through key themes
The following themes represent significant areas of strength in LSTM and draw upon relevant expertise from across all four research departments to ensure best possible outcomes.
Lorem ipsum dolor, sit amet consectetur adipisicing elit. Reprehenderit voluptates voluptatum veritatis distinctio in voluptatibus, obcaecati doloribus saepe dolorem repellendus corporis, tenetur perspiciatis nobis repellat, modi asperiores harum enim laudantium.
Lorem ipsum dolor, sit amet consectetur adipisicing elit. Reprehenderit voluptates voluptatum veritatis distinctio in voluptatibus, obcaecati doloribus saepe dolorem repellendus corporis, tenetur perspiciatis nobis repellat, modi asperiores harum enim laudantium.
Lorem ipsum dolor, sit amet consectetur adipisicing elit. Reprehenderit voluptates voluptatum veritatis distinctio in voluptatibus, obcaecati doloribus saepe dolorem repellendus corporis, tenetur perspiciatis nobis repellat, modi asperiores harum enim laudantium.
Lorem ipsum dolor, sit amet consectetur adipisicing elit. Reprehenderit voluptates voluptatum veritatis distinctio in voluptatibus, obcaecati doloribus saepe dolorem repellendus corporis, tenetur perspiciatis nobis repellat, modi asperiores harum enim laudantium.
Lorem ipsum dolor, sit amet consectetur adipisicing elit. Reprehenderit voluptates voluptatum veritatis distinctio in voluptatibus, obcaecati doloribus saepe dolorem repellendus corporis, tenetur perspiciatis nobis repellat, modi asperiores harum enim laudantium.
Lorem ipsum dolor, sit amet consectetur adipisicing elit. Reprehenderit voluptates voluptatum veritatis distinctio in voluptatibus, obcaecati doloribus saepe dolorem repellendus corporis, tenetur perspiciatis nobis repellat, modi asperiores harum enim laudantium.
Lorem ipsum dolor, sit amet consectetur adipisicing elit. Reprehenderit voluptates voluptatum veritatis distinctio in voluptatibus, obcaecati doloribus saepe dolorem repellendus corporis, tenetur perspiciatis nobis repellat, modi asperiores harum enim laudantium.
Lorem ipsum dolor, sit amet consectetur adipisicing elit. Reprehenderit voluptates voluptatum veritatis distinctio in voluptatibus, obcaecati doloribus saepe dolorem repellendus corporis, tenetur perspiciatis nobis repellat, modi asperiores harum enim laudantium.
Study with us
When you study with us, you will join an institution that has been at the forefront of innovation since its foundation in 1898.
Unsure which course is right for you? Choose your career path and we'll guide you to the best option.
Recruitment week
28 October - 1 November 2024
